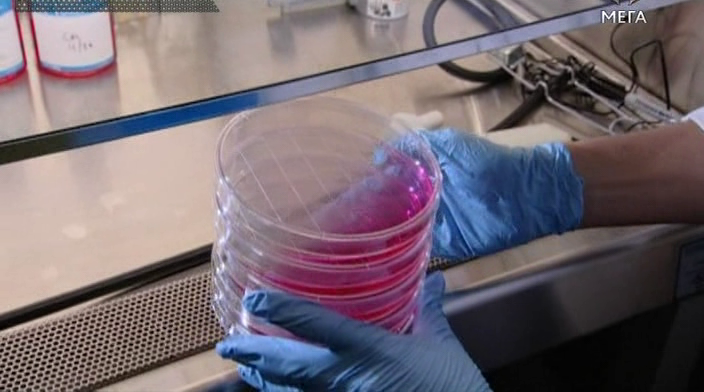

- Якість:SD
- Озвучення:багатоголосий закадровий | Мега
- Режисер:Ian MacMillan, Mina Panic, Гелен Шаріатмадарі
- Актори:Мічіо Каку, Raymond Kurzweil, Браян Кокс, Ali Rezai
Скріншоти
Скоро з'явиться
Популярне
Про що серіал "БіБіСі: Погляд у майбутнє" ?
Доктор Мічіо Каку точно знає, що на нас чекає у найближчому майбутньому. На його думку, вже незабаром ми станемо справжніми правителями навколишнього світу. Це дасть нам не лише необмежені можливості, але й велику відповідальність.У кількох випусках проекту науковець розповість про можливість виникнення штучного інтелекту та те, як він може змінити наше життя; про майбутні відкриття у сфері біотехнологій та продовження людського віку; а також про квантову революцію, яка змінить наше уявлення про світ.
Дивитися серіал "БіБіСі: Погляд у майбутнє" українською в хорошій якості!
UA
ORIG #1
Цей серіал доступний на комп'ютері, телефоні Android, iPhone, iPad, iPod, телевізорі LG Smart TV, Samsung Smart TV, Sony Smart TV, Philips Smart TV, Toshiba Smart TV, Apple TV у будь-який час.
Дата виходу серій "БіБіСі: Погляд у майбутнє"
Мінімальна довжина коментаря – 20 знаків. Поважайте себе та інших!